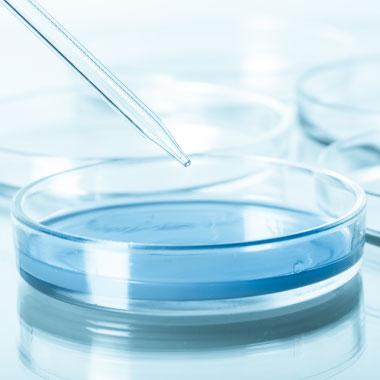

Be yourself; Everyone else is already taken.
— Oscar Wilde.
This is the first post on my new blog. I’m just getting this new blog going, so stay tuned for more. Subscribe below to get notified when I post new updates.
Be yourself; Everyone else is already taken.
— Oscar Wilde.
This is the first post on my new blog. I’m just getting this new blog going, so stay tuned for more. Subscribe below to get notified when I post new updates.
Being physically and rationally fit methods you can achieve nearly everything, from getting down to business effectively, doing tasks cheerfully and settling on the best choices to improve your way of life. Realizing that you have the ability to do such things can doubtlessly assist you with making a superior and increasingly stable future for you and your family. With this stated, a fundamental factor that should be dealt with is your wellbeing. Visit here legionella test
Starting today, there are various infections and sicknesses that can influence one’s wellbeing. These maladies can make life hopeless particularly if the infection influences your mind and body and most exceedingly terrible, on the off chance that it even causes demise. That is the reason an ever increasing number of people are presently changing their way of life, they start eating well dinners, practicing normally and in any event, drinking enough water. Water is basic to the body since it can help reenergize the body and help control blood dissemination. Be that as it may, water can likewise be the wellspring of sicknesses because of Legionella microscopic organisms. Along these lines, to help anticipate Legionella, testing units are required. Recorded underneath are a portion of the benefits of these testing packs.
To anticipate and dispose of Legionnaire’s malady – Above all else, this unit is fundamentally made to counteract and dispose of Legionnaires’ illness. This should be possible effectively by people since some testing packs are proficiently intended to assist people with utilizing these units all alone. Thus, people can take out such malady that can influence their wellbeing and prosperity.
To improve water security – Legionella microscopic organisms is usually identified in high temp water tanks, cooling towers and evaporative condensers of enormous cooling framework. These things are normally found in houses. By utilizing Legionella testing things, high temp water tanks can be sheltered from the microscopic organisms. Also, water is a lot more secure for everybody.
To diminish costs – Hospitalization, drug and medicines are over the top expensive. These medicines can likewise influence your way of life since you have to go to the specialist for customary registration. Along these lines, regarding utilizing Legionella testing units, people can decrease their costs. This is conceivable since these testing packs are genuinely moderate and going to medical clinic for medicines brought about by Legionnaire’s illness is likewise forestalled.
With the utilization of these testing packs, people can effectively keep Legionella microorganisms from influencing their wellbeing. This can likewise assist make with watering sources more secure to guarantee that people can acquire the advantages of utilizing or drinking spotless and solid water. For additional, click here.
This is an example post, originally published as part of Blogging University. Enroll in one of our ten programs, and start your blog right.
You’re going to publish a post today. Don’t worry about how your blog looks. Don’t worry if you haven’t given it a name yet, or you’re feeling overwhelmed. Just click the “New Post” button, and tell us why you’re here.
Why do this?
The post can be short or long, a personal intro to your life or a bloggy mission statement, a manifesto for the future or a simple outline of your the types of things you hope to publish.
To help you get started, here are a few questions:
You’re not locked into any of this; one of the wonderful things about blogs is how they constantly evolve as we learn, grow, and interact with one another — but it’s good to know where and why you started, and articulating your goals may just give you a few other post ideas.
Can’t think how to get started? Just write the first thing that pops into your head. Anne Lamott, author of a book on writing we love, says that you need to give yourself permission to write a “crappy first draft”. Anne makes a great point — just start writing, and worry about editing it later.
When you’re ready to publish, give your post three to five tags that describe your blog’s focus — writing, photography, fiction, parenting, food, cars, movies, sports, whatever. These tags will help others who care about your topics find you in the Reader. Make sure one of the tags is “zerotohero,” so other new bloggers can find you, too.